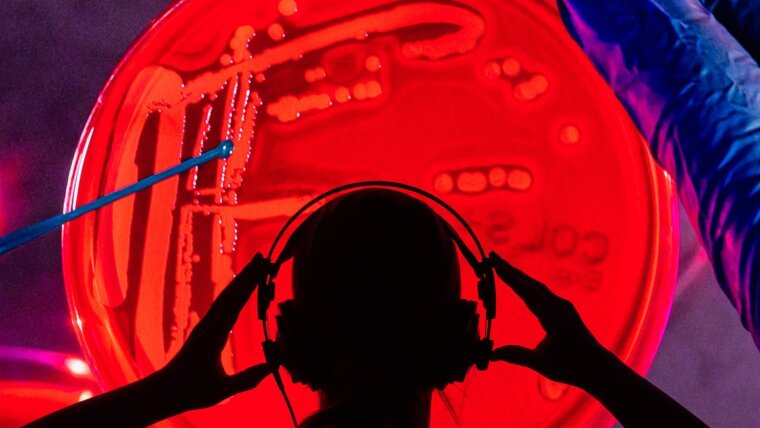
Spectroscopic analysics of a bacteria culture in the lab

This event is in the past.
Event details
Export this event in ICS format
- Start
-
- End
-
- Types of event
- Seminar
- Venue
-
Abbe Center of Photonics
Albert-Einstein-Str 6, Auditorium
07745 Jena
Google Maps site planExternal link
- Video chat
-
Data protection informationpdf, 101 kb
- Language of the event
- English
- Wheelchair access
- Yes
- Public
- Yes